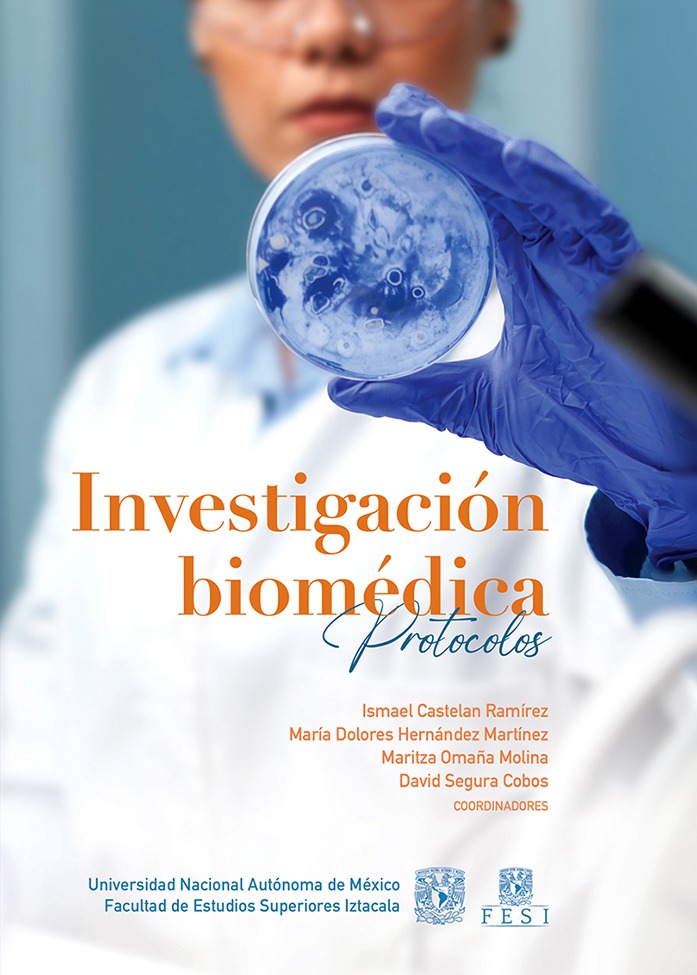

3 resultados / Página 1 / mostrando 1 - 3
ISBN 978-607-642-031-7
Autor:Guzmán Hernández, Elizabeth Alejandrina; Rivera Yáñez, Nelly; Vilches Flores, Alonso Antonio; Romero López, José Pablo; Nieto Yáñez, Óscar de Jesús; Hernandez Martinez, Maria Dolores; Omaña Molina, Maritza Aurelia; Segura Cobos, David; Romero Grijalva, Miriam; Castelan Ramírez, Ismael; Ibarra Montes, María del Rocío
Editorial:Universidad Nacional Autónoma de México
Materia:Ciencias médicas Medicina
Publicado:2025-10-24
Autor:Guzmán Hernández, Elizabeth Alejandrina; Rivera Yáñez, Nelly; Vilches Flores, Alonso Antonio; Romero López, José Pablo; Nieto Yáñez, Óscar de Jesús; Hernandez Martinez, Maria Dolores; Omaña Molina, Maritza Aurelia; Segura Cobos, David; Romero Grijalva, Miriam; Castelan Ramírez, Ismael; Ibarra Montes, María del Rocío
Editorial:Universidad Nacional Autónoma de México
Materia:Ciencias médicas Medicina
Publicado:2025-10-24
ISBN 978-607-587-996-3
Autor:Guzmán Hernández, Elizabeth Alejandrina; Rivera Yáñez, Nelly; Vilches Flores, Alonso Antonio; Romero López, José Pablo; Nieto Yáñez, Óscar de Jesús; Hernandez Martinez, Maria Dolores; Omaña Molina, Maritza Aurelia; Segura Cobos, David; Romero Grijalva, Miriam; Castelan Ramírez, Ismael; Ibarra Montes, María del Rocío
Editorial:Universidad Nacional Autónoma de México
Materia:Ciencias médicas Medicina
Publicado:2025-10-17
Autor:Guzmán Hernández, Elizabeth Alejandrina; Rivera Yáñez, Nelly; Vilches Flores, Alonso Antonio; Romero López, José Pablo; Nieto Yáñez, Óscar de Jesús; Hernandez Martinez, Maria Dolores; Omaña Molina, Maritza Aurelia; Segura Cobos, David; Romero Grijalva, Miriam; Castelan Ramírez, Ismael; Ibarra Montes, María del Rocío
Editorial:Universidad Nacional Autónoma de México
Materia:Ciencias médicas Medicina
Publicado:2025-10-17
ISBN 978-970-96638-6-0
Editorial:Sistema Desarrollador de Mypes
Materia:Investigación
Publicado:2025-11-03
La sustentabilidad social de las micro y pequeñas empresas: el papel del trabajo decente.
Autor:López Hernández, Alma Delia; Muñoz Rivera, Rosa María; Téllez Vázquez, Christiane Aldair; Dimas Díaz, Francelin; Santillán Valdelamar, María Guadalupe; Barrera Rodríguez, Elizabeth; Barrera Pacheco, Lesly Anahí; Reyes Pérez, Diana; Vargas Rivera, Karina; García Esquivel, Yarely; Rodríguez Moreno, Raúl; Ramírez Cortés, Verónica; Piedra Mayorga, Víctor Manuel; Martínez Cano, José Everardo; Acevedo Sánchez, Ismael; Castillo Trejo, Alfredo; Ortega Montiel, María de Lourdes; Tristán Muñiz, Roberto; Gordillo Benavente, Liliana de Jesús; Vega Hernández, Claudia; Domínguez Valdez, Benedicta María; López Palomar, Ma. del Refugio; Maldonado Virgen, Francisco Javier; Rodríguez López, Adriana; García Cueva, Sara Adriana; Ortíz Paniagua, María Luz; Gámez Adame, Luis Carlos; Joya Arreola, Roberto; Casillas Velázquez, María del Carmen; Villalpando Robles, Jorge Orlando; Segovia López, Rito; Chacón Maza, Teofilo; Moya Núñez, Daniel Armando; González Moreno, Cynthia Dinorah; Navarro Alvarado, Alberto; Becerra Bizarrón, LeonarEditorial:Sistema Desarrollador de Mypes
Materia:Investigación
Publicado:2025-11-03